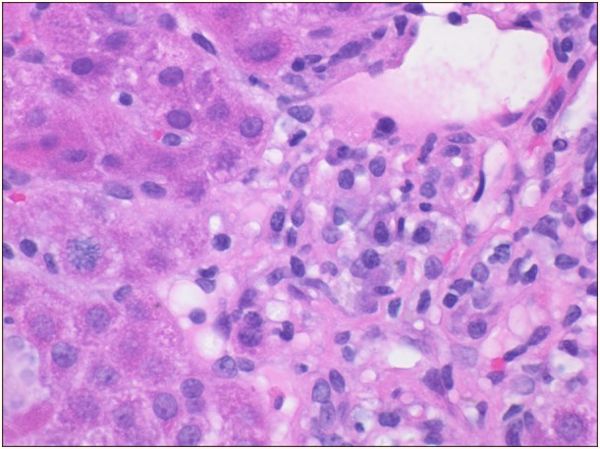
米诺环素引起的肝损害怎么办,药物诱发自身免疫性肝炎

医脉通编译整理,未经授权不得转载。
病例简介
患者,男性,17岁,因恶心、食欲不振、瘙痒、尿色深和巩膜黄疸而急诊入院。否认服用对乙酰氨基酚或酒精,既往无肝炎病史,无药物过敏史,家族未见相关病史。生命体征平稳,体格检查显示巩膜黄疸,未见肝脾肿大。实验室检查显示转氨酶升高(天冬氨酸转氨酶[AST],2229 U / L;丙氨酸转移酶[ALT],2247 U / L)和高胆红素血症(总胆红素,10.2μg/ dL;直接胆红素,5.9μg/ dL),其余检查包括全血细胞计数及肝炎病毒血清学检查未见异常。
患者诉5个月前因*疮痤**,曾口服米诺环素,100μg,每日1次,局部用克林霉素,但均以停药,故请胃肠病科协同会诊。
4天后,患者在胃肠病科接受了评估,此时患者巩膜黄疸和瘙痒持续存在,但食欲不振和恶心已经消退。患者诉体重减轻,约3.2公斤。否认腹痛、容易瘀伤/出血、嗜睡或便秘。实验室检查显示阳性抗平滑肌抗体(1:160滴度)和升高的IgG水平(1,766μg/ dL),转氨酶(ALT,3227 U / L; AST,3547 U / L)和直接高胆红素血症加重(总胆红素,21.8μg/ dL;直接胆红素,13.98μg/ dL),但肝功能正常。其他检测正常包括:抗核抗体(ANA)、抗肝肾微粒体(抗LKM)抗体、血浆铜蓝蛋白、感染滴度(Epstein-Barr病毒皆在正常范围内。
腹部超声多普勒超声检查:没有发现肝脏或胆道异常,但有轻微的脾肿大。肝脏活组织显示明显的玫瑰花结,浆细胞增多,窦状隙成熟淋巴细胞轻微增加,2期门静脉周围纤维化,无桥接或肝硬化结节,无嗜酸性粒细胞存在,无可染色铁、铜或A1AT小球。这些组织学发现与中度至重度急性慢性肝炎(总体3至4级)一致,提示自身免疫性肝炎。根据这些发现和整体临床表现,患者被诊断为继发于米诺环素的药物诱导的自身免疫性肝炎。

图1玫瑰花结和少量窦状成熟淋巴细胞
图2 血浆细胞增多

图3 网状染色显示门周纤维化
在米诺环素停药后约两周,转氨酶达到峰值,ALT为3422 U / L,AST为3909 U / L,直接胆红素达到峰值,为17.54μg/ dL。随后患者开始服用泼尼松,在开始治疗后24小时内,转氨酶和直接高胆红素血症均有显著改善,12周后实验室完全恢复正常。停用泼尼松后,肝炎没有复发。患者未进行重复肝脏活检,仅临床上定期监测肝功能检查。
讨论
米诺环素诱导的自身免疫性肝炎通常在长期暴露于药物后发生。平均发病时间为2年,但可能发生在几个月内。临床特征包括发烧、多关节痛、皮疹、厌食、疲劳、恶心、腹痛和黄疸。该疾病的血清学标志物与特发性自身免疫性肝炎相似,如存在抗核抗体和抗平滑肌抗体、免疫球蛋白水平升高。米诺环素诱导的自身免疫性肝炎的组织学特征与自身免疫性肝炎相同,典型表现是慢性活动性肝炎伴门周淋巴浆细胞炎症和零星坏死。桥接纤维化和肝硬化是不常见的发现。米诺环素诱导的肝炎在女性中发生的频率是男性的两倍。与男性相比,女性出现症状的时间也较短,米诺环素治疗的持续时间较短。
症状和实验室异常通常在停药后3个月内消退。根据疾病的严重程度,可能需要使用口服皮质类固醇,如泼尼松。类固醇应持续多月,最终逐渐减量。在某些情况下,肝病可能非常严重,需要使用免疫调节剂,如硫唑嘌呤。在停用米诺环素和至少1个月使用皮质类固醇后,转氨酶无改善的情况下应考虑这种额外的治疗。治疗开始后,患者应在实验室值正常化后临床随访1年。除非患者再次接受米诺环素的攻击,否则通常不会发生疾病复发。
虽然使用米诺环素的肝脏疾病的总体风险很低,但是儿科医生和初级保健提供者应了解药物治疗青春期*疮痤**的常见风险。目前还没有关于米诺环素治疗期间监测的建议。必须尽早识别米诺环素的不良反应,因为停止用药会导致临床快速改善。当米诺环素治疗期间出现肝功能障碍时,提供者应考虑药物诱导的自身免疫性肝炎的可能性。
医脉通编译整理自:Harmon E G , Mcconnie R , Kesavan A . Minocycline-Induced Autoimmune Hepatitis: A Rare But Important Cause of Drug-Induced Autoimmune Hepatitis[J]. Pediatric Gastroenterology Hepatology & Nutrition, 2018, 21(4).